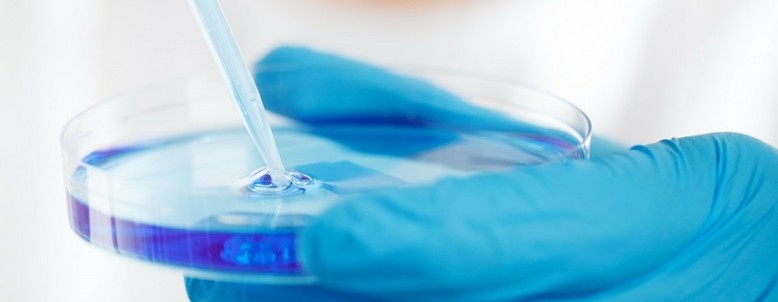

Hauptmenü:
Kurzhaar
Weitere Links
Mittellanghaar
Weitere Links
Langhaar
Weitere Links
Fotos Jake
Weitere Links
Fotos Nikki
Weitere Links
Fotos Aisha
Weitere Links
IMPRESSUM
Copyright © 2013-2015 Perserkitten.ch
Perserkitten.ch
Lara & Kilian Portmann
Oberburgstrasse 110
3400 Burgorf
ERREICHBARKEIT
Wir geben unsere Kitten nur an Haushalten mit Katzen- einrichtungen ab.
Wenn Sie Fragen zu unseren Kitten haben oder weitere Informationen benötigen, zögern Sie nicht uns zu kontaktieren.
Our Kitties - Your best Friends
Kitten
Webseite
Montag:
Dienstag:
Mittwoch:
Donnerstag:
Freitag:
Samstag:
Bilder, Text und Logo dürfen nur mit unserer Zustimmung weiter verwendet werden.
18:00-22:00Uhr
18:00-22:00Uhr
18:00-22:00Uhr
18:00-22:00Uhr
18:00-22:00Uhr
10:00-20:00Uhr
Besuche sollten vorgängig per Mail oder Telefon angemeldet werden.
Durchsuchen
Sie suchen einen speziellen Beitrag, durchsuchen Sie unsere Webseite.